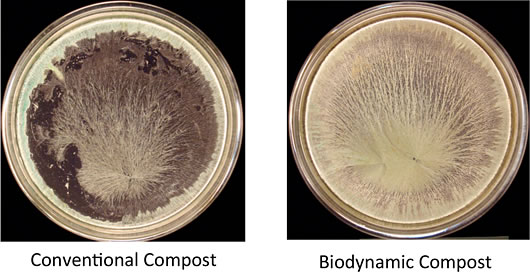

Some of the basic principles of Biodynamics are:
Reading the book of nature
Everything in nature reveals something of its essential character in its form and gesture. Careful observations of nature -- in shade and full sun, in wet and dry areas, on different soils, will yield a more fluid grasp of the elements.
Cosmic rhythms
The light of the sun, moon, planets and stars reaches the plants in regular rhythms. Each contributes to the life, growth and form of the plant. By understanding the gesture and effect of each rhythm, we can time our ground preparation, sowing, cultivating and harvesting to the advantage of the crops we are raising.
Plant life is intimately bound up with the life of the soil
Biodynamics recognises that soil itself can be alive, and this vitality supports and affects the quality and health of the plants that grow in it. Therefore, one of the fundamental efforts of Biodynamics is to build up stable humus in our soil through composting. Chemical agriculture has developed short-cuts to producing quantity by adding soluble minerals to the soil. The plants take these up via water, thus by-passing their natural ability to seek from the soil what is needed for health, vitality and growth. The result is a deadened soil and artificially stimulated growth. Biodynamics grows food with a strong connection to a healthy, living soil.
An alternative view of nutrition
We gain our physical strength from the process of breaking down the food we eat. The more vital our food, the more it stimulates our own activity. Thus, Biodynamic farmers and gardeners aim for intrinsic quality, and not only quantity or superficial standards.
Medicine for the earth
Rudolf Steiner introduced what are known as biodynamic preparations. These function as medicin for the soil. The beneficial effects of the preparations have been verified scientifically.
The Farm as the basic unit of agriculture
Biodynamic farming poses the ideal of the self-contained farm: that there should be just the right number of animals to provide manure for fertility, and these animals should, in turn, be fed from the farm. Vegetable waste, manure, leaves, food scraps - all of these contain precious vitality which can be held and put to use for building up the soil if they are handled wisely. Thus, composting is a key activity in biodynamic work. The farm is also a teacher, and provides the educational opportunity to imitate nature's wise self-sufficiency within a limited area.
Connecting citizens and farmers
Steiner emphasised the absurdity of agricultural economics being determined by people who have never actually raised crops or managed a farm. The Community Supported Agriculture (CSA) movement grew out of the biodynamic movement and is spreading rapidly. Thus consumers become connected with the real needs of the earth, the farm and the community.
(Based on "An Introduction To Biodynamic Agriculture" in Stella Natura by Sherry Wildfeuer (1995))